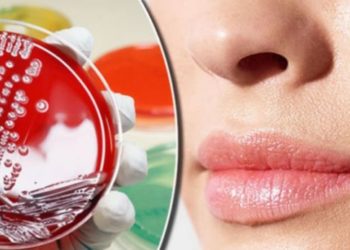

Shëndet
Lajme.al ju sjell edhe këshilla të rëndësishme në mënyrë që jeta juaj të bëhet sa më e shëndetshme. Lexoni këshilla shëndetësore nga doktorë të njohur nga vendi dhe bota.
Zgjidhja e mahnitshme për qimet e fytyrës!
Kjo është një recetë e shpikur nga një grua e cila do t’ju shpëtojë përgjithmonë nga qimet dhe do t’ju...
Lexo më shumëDetailsTrup të bukur për pushime? Ja pija që ju ndihmon të dobësoheni lehtë
Konsumi i pijeve me çaj jeshil është bërë një nga zgjidhjet më të mira mes atyre që kërkojnë të arrijnë...
Lexo më shumëDetailsKy është momenti më i mirë për të mbetur shtatzënë
Edhe për meshkujt, mosha është armiku i pjellorisë. Prandaj, është e gabuar të presësh shumë kohë për një fëmijë. Tek...
Lexo më shumëDetailsZbulim i papritur: Askush nuk e priste që kjo të fshihej brenda hundës së njeriut!
Prej kohësh, shkencëtarët paralajmërojnë se duhen antibiotikë të rinj, pasi mikrobet po krijojnë rezistencë ndaj atyre aktualë, që në shumicën...
Lexo më shumëDetailsHistoria e gruas “heroinë”, si i mbijetoi dy herë luftës me kancerin
Vlerën e jetës e kuptojmë më së shumti atëherë kur fati na vendos përballë vdekjes. Kështu ka ndodhur edhe me...
Lexo më shumëDetails6 kuriozitete që nuk i dini për organin gjenital të mashkullit
-Sa më shumë kalojnë vitet, aq më pak i ndjeshëm bëhet organi gjenital i mashkullit. Kjo për shkak se ashtu...
Lexo më shumëDetailsRreziku që udhëtarët në avion nuk i kushtojnë rëndësi
Nëse jeni një ndër ata udhëtarë të cilët më shumë dëshirojnë të ulen afër dritares, do të duhej kushtuar kujdes...
Lexo më shumëDetailsZbulohet se çfarë i ndodh trurit pak minuta para vdekjes
Sipas zbulimit të një ekipi neurologësh nga spitali i “Charité-Universitätsmedizin Berlin”, një valë aktiviteti elektrik që emërtohet “tsunami cerebral” duket...
Lexo më shumëDetailsNdotja në Shqipëri, 630 raste me kancer në vit
Mjekët japin alarmin për vdekjet nga ndotja e ajrit. Gjatë një viti, në Shqipëri janë prekur 630 persona nga kanceri...
Lexo më shumëDetailsMrekullitë që bën biçikleta për shëndetin
Aktiviteti fizik është i këshillueshëm pasi sjell mjaft të mira për shëndetin tonë. Mjekët veçojnë përdorimin e biçikletës si një...
Lexo më shumëDetails